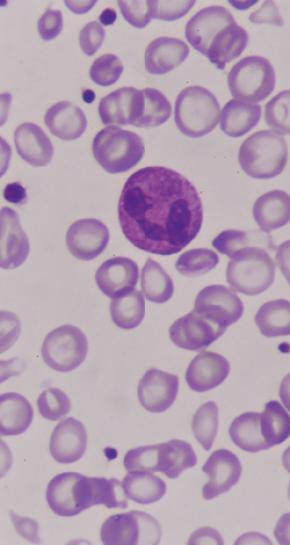

Wat is hemofilie?
Hemofilie is een zeldzame ziekte van het bloed. Als je hemofilie hebt, krijg je snel bloedingen. Dit komt omdat je een stollingseiwit mist dat ervoor zorgt dat het bloed stolt.
Het is niet zo dat je als je hemofilie hebt, je bij het kleinste wondje overvloedig bloedt. Met hemofilie bloed je niet sneller dan normaal, maar wel langer omdat je bloed niet genoeg stollingsfactoren bevat.
Oppervlakkige wondjes zijn meestal onschuldig. Inwendige bloedingen daarentegen zijn ernstiger en die kunnen al optreden na een ogenschijnlijke lichte verwonding.
Ook bloedingen in de gewrichten of de spieren komen vaak voor. Deze kunnen erg pijnlijk zijn, richten vaak onherstelbare schade aan en kunnen ervoor zorgen dat je gewrichten versneld verouderen en dat je blijvend invalide raakt. Tot slot kunnen er levensbedreigende bloedingen in je vitale organen, zoals de hersenen, ontstaan.
Wie krijgt het?
Hemofilie komt over de hele wereld voor. Er zijn twee soorten: type A en B. In Nederland hebben ongeveer 1600 mensen hemofilie. Meestal is hemofilie erfelijk, maar je kunt het ook op latere leeftijd krijgen.
Bijna alle hemofiliepatiënten zijn van het mannelijke geslacht. Vrouwen zijn meestal alleen draagster. Wanneer één van de ouders een hemofiliepatiënt of draagster is lopen hun kinderen vijftig procent kans om de ziekte ook te krijgen (jongens) of om ook drager te worden (meisjes).
Meestal krijgen mensen de diagnose tijdens hun peuter- of kinderjaren.
Wat gaat er mis bij mensen met hemofilie?
Mensen met hemofilie hebben te weinig stollingseiwitten. In je lichaam is een nauwkeurig systeem aanwezig (hemostase) dat ervoor zorgt dat bloed alleen stolt wanneer je een wondje hebt en dat het stolsel weer afgebroken wordt wanneer het niet meer nodig is. Stolling is een belangrijk onderdeel van de hemostase.
De bloedstolling bestaat uit een serie stollingseiwitten die elkaar activeren, zodat uiteindelijk een stolsel gevormd wordt. Deze stollingseiwitten worden stollingsfactoren genoemd en zijn met Romeinse cijfers genummerd. Bij hemofilie type A mis je als patiënt stollingsfactor VIII en bij hemofilie type B stollingsfactor IX. De ernst van de ziekte wordt bepaald door de hoeveelheid factor VIII of IX die je als patiënt hebt.
Behandeling van hemofilie
Hemofilie is niet te genezen, maar wel behandelbaar. Als je hemofilie hebt, word je behandeld door het injecteren van het missende stollingseiwit.
Er zijn middelen waarbij dit eiwit uit donorbloed wordt gewonnen en er bestaan ook nagemaakte kunstmatige middelen (recombinant).
Mensen met ernstige hemofilie, worden twee tot drie keer per week behandelend met stollingseiwitten. Bij operaties wordt het missende eiwit ook vlak van tevoren toegediend, om bloedingen te voorkomen.
Wanneer mensen verwondingen oplopen, moeten zij het missende eiwit meteen toegediend krijgen. Mensen met hemofilie kunnen zich over het algemeen zelf thuis behandelen en bij kinderen kunnen de ouders dit doen.
Vroeger was er geen behandeling en in de jaren ’60 van de vorige eeuw was de gemiddelde levensverwachting van mensen met hemofilie dertig jaar. Nu is deze boven de 70 en ook is de levenskwaliteit fors toegenomen.




